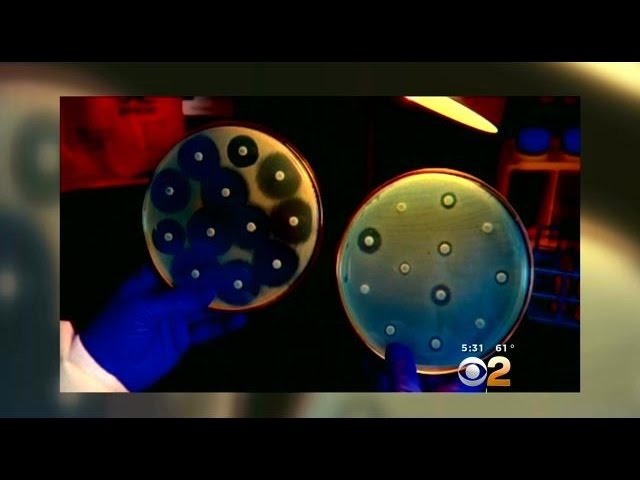

Channel / Source:
KCAL News
Published: 2015-02-20
Source: https://www.youtube.com/watch?v=VZEWD2Zj9LI